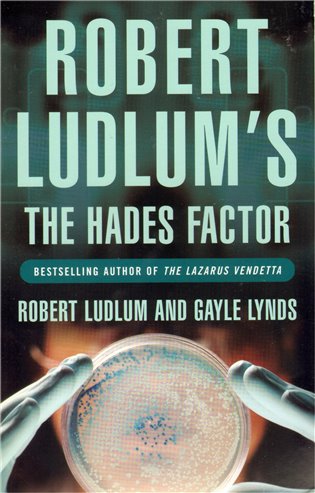
The Hades Factor

Nalezené produkty
Nalezené kategorie
Nalezení autoři
Nalezené články: 140
Košík
je prázdný
je prázdný
The Hades Factor
Robert Ludlum
Cena v prodejně:
159 Kč
Cena při objednávce v e-shopu:
-16 Kč
143 Kč
U dodavatele
poslední kusy na objednávku.
V prodejně do 4 dnů
K vyzvednutí pá 3.7 13:00
Odesíláme do 4 dnů
od 59 Kč, dodání út 7.7
Kdy můžu zboží mít?
Produkt je u dodavatele, odesíláme ho ihned po naskladnění.
Osobní odběr | ||
| Prodejna Benešov - ZDARMA | pá 3.7 | |
Výdejní místa | ||
| One Box, One Point | 59 Kč | út 7.7 |
| Zásilkovna | 69 Kč | út 7.7 |
| Zásilkovna SK | 95 Kč | st 8.7 |
Dodání na adresu v ČR | ||
| Stažení online | 0 Kč | pá 3.7 |
| One Curier | 65 Kč | út 7.7 |
| Zásilkovna - domů | 99 Kč | út 7.7 |
| Zásilkovna SK - domů | 139 Kč | st 8.7 |
Uvedený termín u dodání domů a na výdejní místa je orientační. Balíček může přijít v rozmezí dvou dní po termínu.
A homeless man in Boston, an Army Major in California, and a teenage girl in Atlanta all die suddenly and painfully - each a victim of an unknown doomsday virus. For three days, a team of scientists in a US government laboratory has been frantically trying to unlock the virus's secrets. Lt. Col. Jonathan 'Jon' Smith, a leading researcher from the lab, barely survives a series of well-orchestrated attempts made on his life. When he discovers that the virus has claimed its fourth victim, his fianc?e, he is devastated and enraged. Smith quickly uncovers evidence that his lover's death was no accident. But wherever he turns, some unseen force blocks his quest for information. Not knowing whom to trust, Smith assembles a private team to search for the truth behind the deadly virus. While the death toll mounts, their quest leads to the highest levels of power and the darkest corners of the earth, as they match wits with a determined genius - and as the future of the world lies in the balance.
| EAN | 9781407219912 |
|---|---|
| ISBN | 9781407219912 |
| Datum vydání | 16. 12. 2009 |
| Vazba | brožovaná vazba |
| Počet stran | 432 |
| Počet stran: | 432 |
| Nakladatelství: | Orion Publishing Co |
| Jazyk: | anglicky |